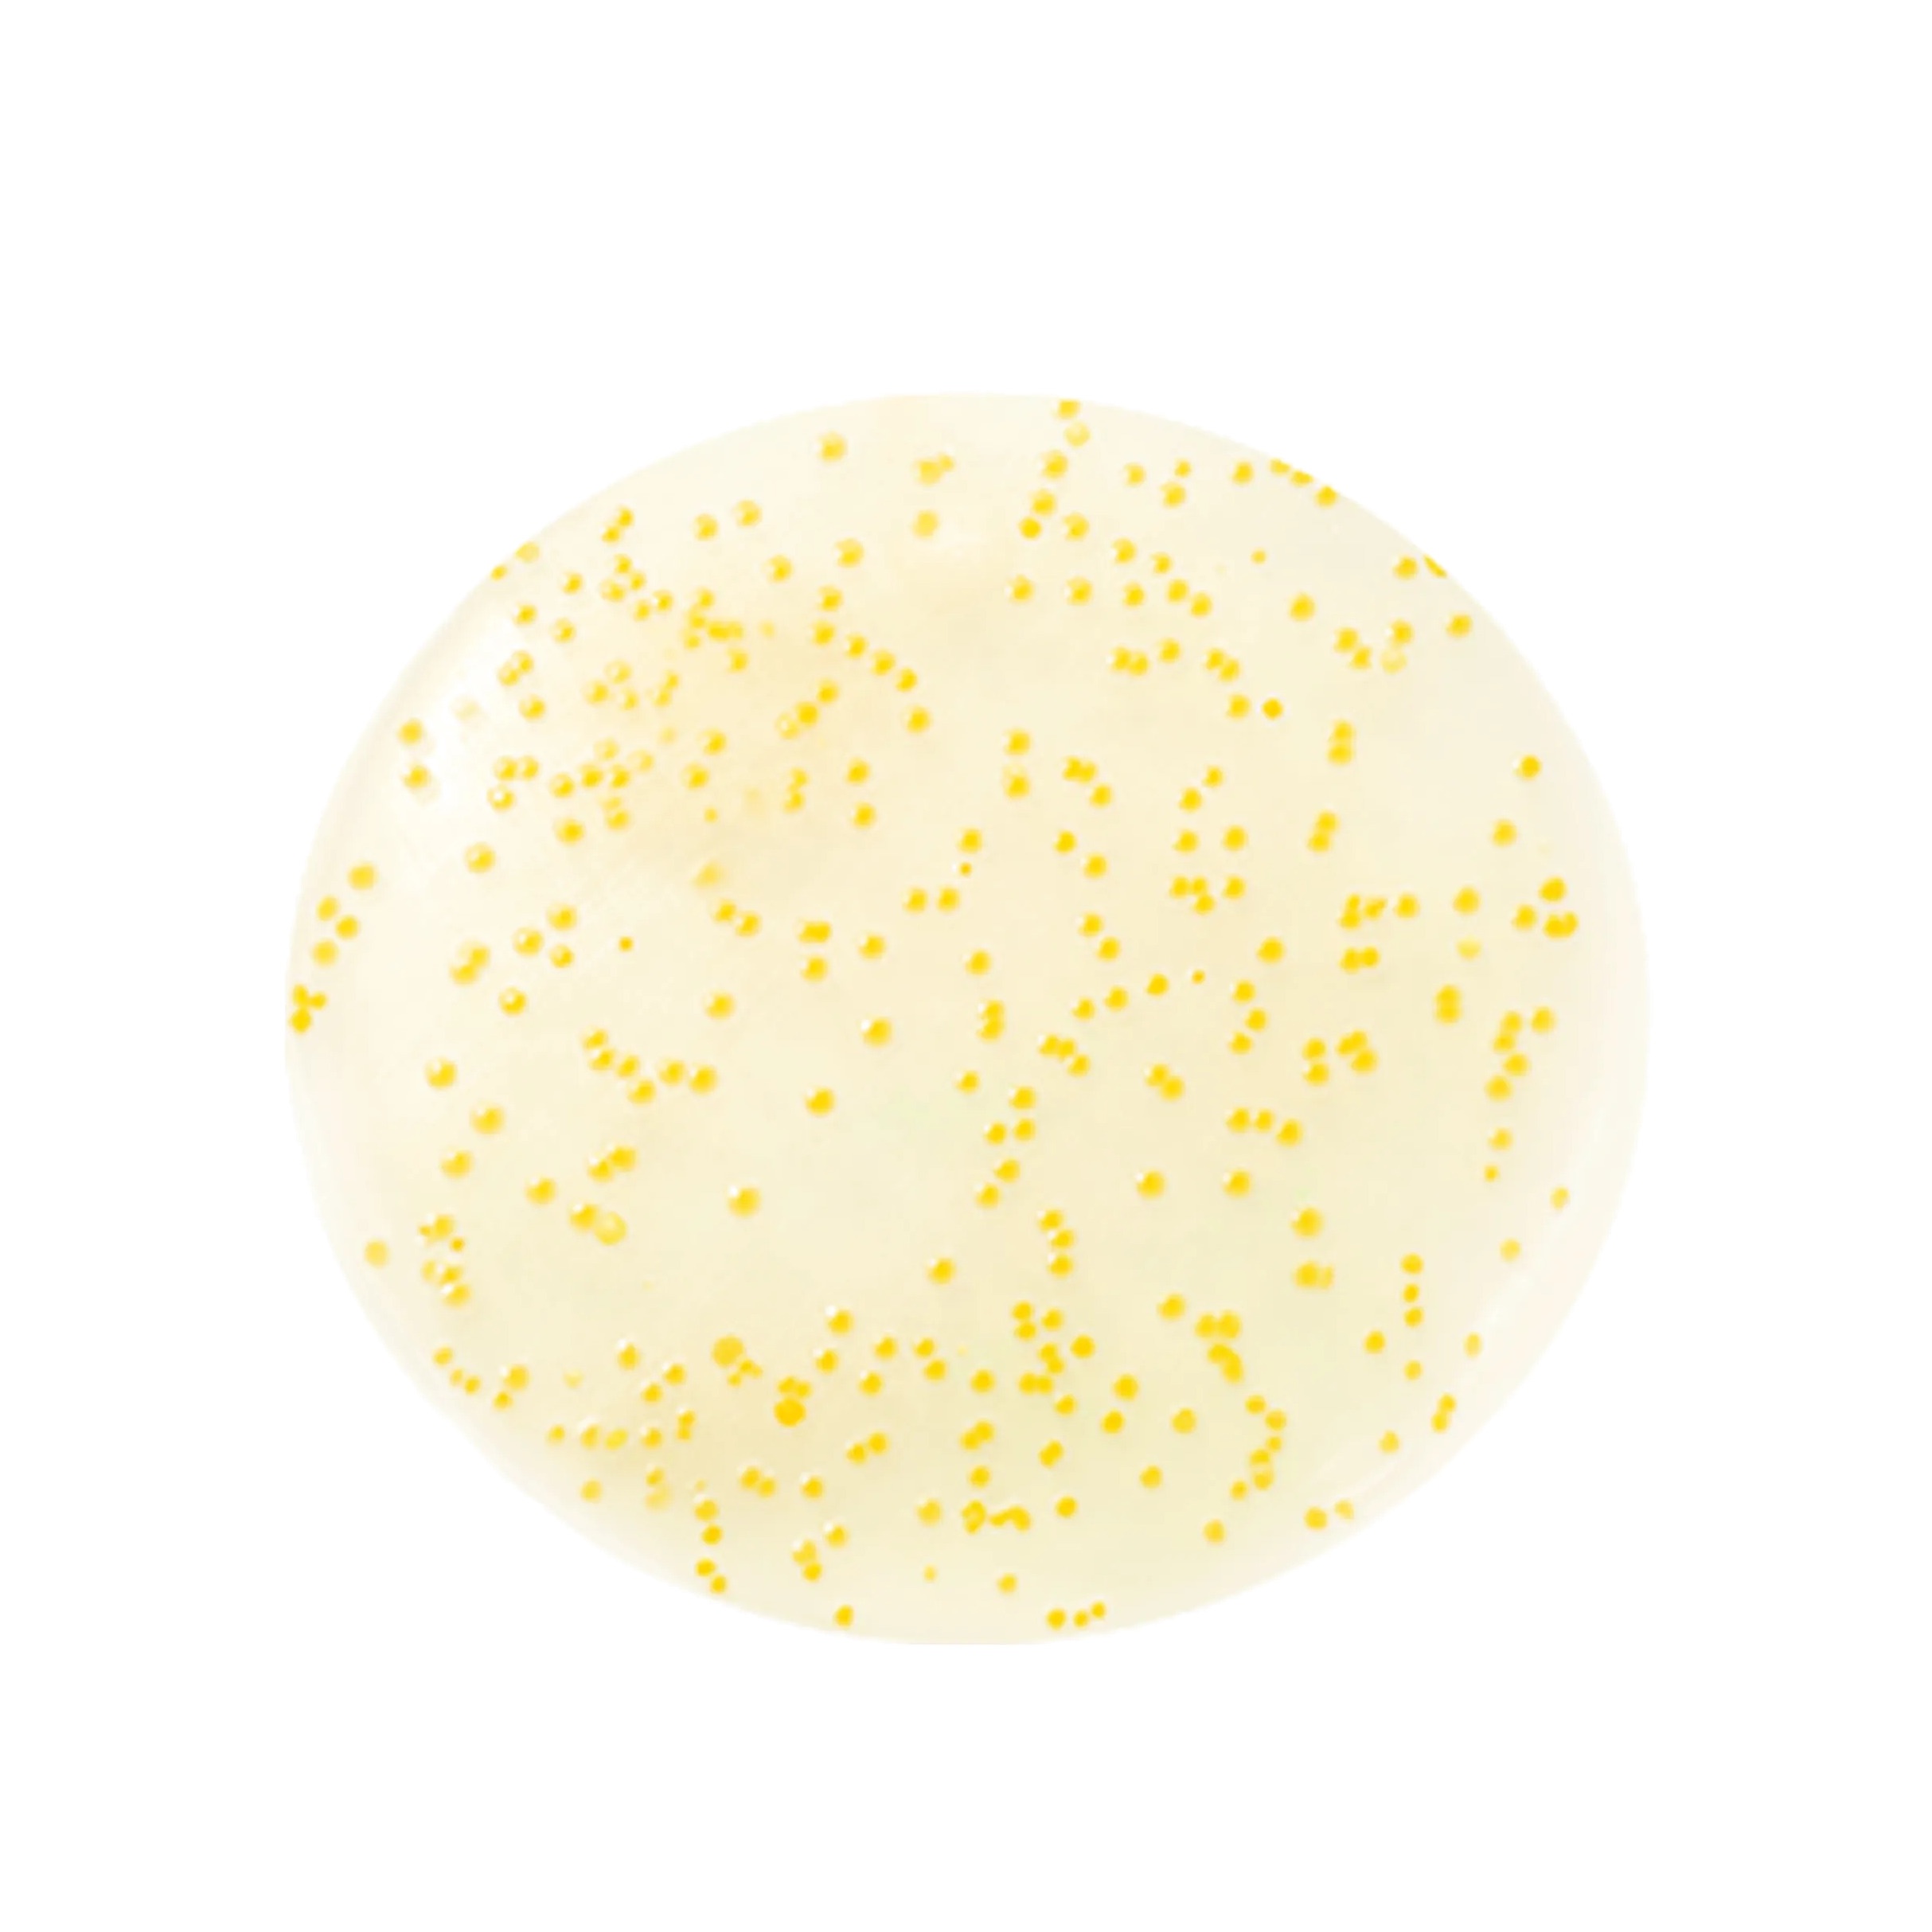
Сыворотка капсульная Vita Toning Capsule Serum купить в VISAGEHALL

Популярные
A
B
C
D
E
F
G
I
J
K
L
M
N
O
P
Q
R
S
T
V
А - Я

4 платежа ×
562 ₽
Сыворотка уменьшает видимость темных пятен и гиперпигментации, улучшает тон кожи и разглаживает мелкие морщины. Благодаря инкапсулированным липосомальным витаминам, она заметно осветляет и заряжает кожу энергией.
Для оптимизации усвоения питательных компонентов d'Alba использовала инновационную трехступенчатую технологию Mega Nano Liposome.
Эта антивозрастная сыворотка заметно уменьшает видимость темных пятен и гиперпигментации, тусклости кожи и мелких морщин всего за 2 недели. Откройте для себя эту многофункциональную формулу для более яркого, упругого и гладкого цвета лица.
Доставим заказ уже сегодня>
4 платежа ×
562 ₽
Мастхэв Малики Кунниевой

d'Alba
Спрей сыворотка мультифункциональная
1850 ₽ 3700 ₽
Мастхэв Малики Кунниевой

d'Alba
Спрей сыворотка мультифункциональная
1850 ₽ 3700 ₽
Вы уверены, что хотите отменить заказ?
Да, отменить



подарочный сертификат

Поздравление
отправитель
Cookie ("куки") – небольшой объем данных, отсылаемый Сайтом/Приложением браузеру, и который сохраняет их на Вашем устройстве, например, данные о том, какие страницы.
Вы посетили, адреса сторонних интернет-сайтов, с которых совершен переход. Информация из браузера отсылается Сайту/Приложению каждый раз, когда браузер запрашивает страницу. Это позволяет веб-серверу Сайта/Приложения идентифицировать и отслеживать данные браузера.
Администрация Сайта для анализа посещаемости настоящего Сайта использует Яндекс.Метрик, которые формируют статистическую и другую информацию о сайте, используя файлы-cookie, которые хранятся в компьютерах пользователей. Эта информация используется для составления отчетов об использовании сайта. Полученные данные хранятся в Яндексе.
Политику конфиденциальности Яндекс можно посмотреть в сети Интернет по адресу http://legal.yandex.ru/confidential/.
Ваш отзыв важен: поделитесь впечатлениями о работе консультанта, а мы начислим бонусы за покупку.
Спасибо!
Бонус в размере 1% от суммы покупки будет начислен на вашу карту лояльности
Оставить отзыв
Оцените товар
Мы используем файлы cookies и технологии веб-аналитики для улучшения работы сайта и удобства его использования. Продолжая пользоваться сайтом и нажимая «Принять», вы подтверждаете использование cookies вашего браузера и соглашаетесь с политикой обработки персональных данных.
